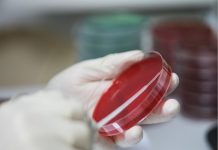

INFOMEDICA
Oamenii de ştiinţă se folosesc de machine learning (sisteme de învăţare automatizată) pentru a detecta modul în care regiunile din creier se activează...
Celule cerebrale umane, implantate în şoareci pentru a analiza tulburările psihiatrice, într-un studiu coordonat...
Oamenii de ştiinţă din Statele Unite, coordonaţi de un cercetător româno-american, au reuşit să implanteze un tip de celule cerebrale umane, denumite organoide, în...
Sanofi va cere aprobarea vaccinului său anti-Covid pe bază de proteine în UE și SUA
Comapania farmaceutică franceză Sanofi și partenerul său britanic GlaxoSmithKline (GSK) au anunțat că intenționează să depună datele de la studiile lor clinice din faza...
Originea noului coronavirus este în continuare „neclară”
Originea noului coronavirus este în continuare neclară şi nu există încă suficiente dovezi care să afirme în mod concludent dacă acesta a apărut în...
Infomedica
• Despre grupa de sânge 0 se spune că este cea mai veche, cea pe care o aveau primii oameni, locuitori ai peşterilor. Strămoşii noştri...
I n f o m e d i c a
La vârste fragede, copiii nu prea fac diferența între poftă, foame și apetit, iar ceasul lor biologic nu este potrivit după al oamenilor mari....
Grupa sanguină poate să determine severitatea cazurilor de COVID-19
Oamenii de ştiinţă germani au descoperit că grupa sanguină a unei persoane poate să determine gradul în care COVID-19, o maladie respiratorie potenţial fatală...
I n f o m e d i c a
Smartphone-ul poate deveni un instrument de siguranță, învățare, autonomie și conectare socială dacă este introdus treptat, cu reguli clare pentru copii și repere ferme...
Copiii şi vârstnicii – cei mai afectaţi de trecerea la ora de iarnă
Trecerea la ora de iarnă aduce o schimbare importantă pentru organism. Ceasul se dă cu o oră înapoi, teoretic vom fi mai odihniți, însă...
INFOMEDICA
Frunzele de dafin dau un gust aparte mâncărurilor, dar pot fi utilizate şi ca medicament natural pentru mai multe boli. Acestea fac bine...